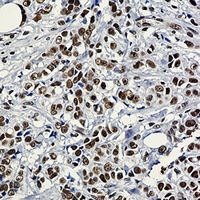

Product Name :
HSF1 Rabbit monoclonal antibody Background :
All organisms respond to increased temperatures and other environmental stresses by rapidly inducing the expression of highly conserved heat shock proteins (HSPs) that serve as molecular chaperones to refold denatured proteins and promote the degradation of damaged proteins. Heat shock gene transcription is regulated by a family of heat shock factors (HSFs), transcriptional activators that bind to heat shock response elements (HSEs) located upstream of all heat shock genes. HSEs are highly conserved among organisms and contain multiple adjacent and inverse iterations of the pentanucleotide motif 5'-nGAAn-3'. HSFs are less conserved and share only 40% sequence identity. Vertebrate cells contain four HSF proteins: HSF1, 2 and 4 are ubiquitous, while HSF3 has only been characterized in avian species. HSF1 induces heat shock gene transcription in response to heat, heavy metals, and oxidative agents, while HSF2 is involved in spermatogenesis and erythroid cell development. HSF3 and HSF4 show overlapping functions with HSF1 and HSF2. The inactive form of HSF1 exists as a monomer that localizes to both the cytoplasm and nucleus, but does not bind DNA . In response to stress, HSF1 becomes phosphorylated, forms homotrimers, binds DNA and activates heat shock gene transcription. HSF1 activity is positively regulated by phosphorylation of Ser419 by PLK1, which enhances nuclear translocation, and phosphorylation of Ser230 by CaMKII, which enhances transactivation. Alternatively, HSF1 activity is repressed by phosphorylation of serines at 303 and 307 by GSK3 and ERK1, respectively, which leads to binding of 14-3-3 protein and sequestration of HSF1 in the cytoplasm. In addition, during attenuation from the heat shock response, HSF1 is repressed by direct binding of Hsp70, HSP40/Hdj-1, and HSF binding protein 1 (HSBP1). Product :
Liquid in 50mM Tris-Glycine (pH 7.4), 0.15M NaCl, 50% Glycerol, 0.01% Sodium azide and 0.05% BSA. Storage&Stability :
Store at 4°C short term. Aliquot and store at -20°C long term. Avoid freeze-thaw cycles. Specificity :
Recognizes endogenous levels of HSF1 protein. Immunogen :
A synthetic peptide of human HSF1 Conjugate :
Unconjugated Modification :
Unmodification
HSF1 Rabbit monoclonal antibody Background :
All organisms respond to increased temperatures and other environmental stresses by rapidly inducing the expression of highly conserved heat shock proteins (HSPs) that serve as molecular chaperones to refold denatured proteins and promote the degradation of damaged proteins. Heat shock gene transcription is regulated by a family of heat shock factors (HSFs), transcriptional activators that bind to heat shock response elements (HSEs) located upstream of all heat shock genes. HSEs are highly conserved among organisms and contain multiple adjacent and inverse iterations of the pentanucleotide motif 5'-nGAAn-3'. HSFs are less conserved and share only 40% sequence identity. Vertebrate cells contain four HSF proteins: HSF1, 2 and 4 are ubiquitous, while HSF3 has only been characterized in avian species. HSF1 induces heat shock gene transcription in response to heat, heavy metals, and oxidative agents, while HSF2 is involved in spermatogenesis and erythroid cell development. HSF3 and HSF4 show overlapping functions with HSF1 and HSF2. The inactive form of HSF1 exists as a monomer that localizes to both the cytoplasm and nucleus, but does not bind DNA . In response to stress, HSF1 becomes phosphorylated, forms homotrimers, binds DNA and activates heat shock gene transcription. HSF1 activity is positively regulated by phosphorylation of Ser419 by PLK1, which enhances nuclear translocation, and phosphorylation of Ser230 by CaMKII, which enhances transactivation. Alternatively, HSF1 activity is repressed by phosphorylation of serines at 303 and 307 by GSK3 and ERK1, respectively, which leads to binding of 14-3-3 protein and sequestration of HSF1 in the cytoplasm. In addition, during attenuation from the heat shock response, HSF1 is repressed by direct binding of Hsp70, HSP40/Hdj-1, and HSF binding protein 1 (HSBP1). Product :
Liquid in 50mM Tris-Glycine (pH 7.4), 0.15M NaCl, 50% Glycerol, 0.01% Sodium azide and 0.05% BSA. Storage&Stability :
Store at 4°C short term. Aliquot and store at -20°C long term. Avoid freeze-thaw cycles. Specificity :
Recognizes endogenous levels of HSF1 protein. Immunogen :
A synthetic peptide of human HSF1 Conjugate :
Unconjugated Modification :
Unmodification
-
 Western blot analysis of HSF1 expression in Hela (A), Jurkat (B) whole cell lysates.
Western blot analysis of HSF1 expression in Hela (A), Jurkat (B) whole cell lysates. -
Immunohistochemical analysis of HSF1 staining in human breast carcinoma formalin fixed paraffin embedded tissue section. The section was pre-treated using heat mediated antigen retrieval with sodium citrate buffer (pH 6.14). The section was then incubated with the antibody at room temperature and detected using an HRP conjugated compact polymer system. DAB was used as the chromogen. The section was then counterstained with haematoxylin and mounted with DPX.
Immunohistochemical analysis of HSF1 staining in human breast carcinoma formalin fixed paraffin embedded tissue section. The section was pre-treated using heat mediated antigen retrieval with sodium citrate buffer (pH 6.14). The section was then incubated with the antibody at room temperature and detected using an HRP conjugated compact polymer system. DAB was used as the chromogen. The section was then counterstained with haematoxylin and mounted with DPX.
Bioworld Biotech only provide peptides for our antibodies and do not provide additional peptide customization services.
Price/Size :
USD 368/1mg/vial
Tips:
For phospho antibody, we provide phospho peptide(0.5mg) and non-phospho peptide(0.5mg).Describe :
Blocking peptides are peptides that bind specifically to the target antibody and block antibody binding. These peptide usually contains the epitope recognized by the antibody. Antibodies bound to the blocking peptide no longer bind to the epitope on the target protein. This mechanism is useful when non-specific binding is an issue, for example, in Western blotting (WB) and Immunohistochemistry (IHC). By comparing the staining from the blocked antibody versus the antibody alone, one can see which staining is specific; Specific binding will be absent from the western blot or IHC performed with the neutralized antibody.Formula:
Synthetic peptide was lyophilized with 100% acetonitrile and is supplied as a powder. Reconstitute with 0.1 ml DI water for a final concentration of 10 mg/ml.The purity is >90%,tested by HPLC and MS.
Storage:
The freeze-dried powder is more stable. For short time at 2-8°C. For long term storage store at -20°C.
Note :
This product is for research use only (RUO only). Not for use in diagnostic or therapeutic procedures.
 HSF1 Rabbit monoclonal antibody
HSF1 Rabbit monoclonal antibody  Datasheet
Datasheet COA
COA MSDS
MSDS SHIP
SHIP